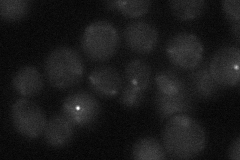
YOR058C
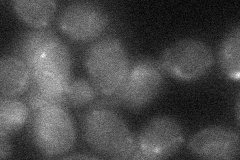
YOR058C

View description
Mitotic spindle midzone localized microtubule-associated protein (MAP) family member; required for spindle elongation and stabilization; undergoes cell cycle-regulated degradation by anaphase promoting complex; potential Cdc28p substrate
Localization:
Intensity:
Fold change:
Significance:
-
C’ GFP library in SD

below threshold16.72 -
N' NOP1pr-GFP in SD

punctate33.5128 -
N' TEF2pr-mCherry in SD

punctate7.90408 -
N' NATIVEpr-GFP in SD
punctate20.0684 -
N' TEF2pr-VC and Cyto-VN in SD
below threshold23.4268 -
C’ GFP library in SD+DTT

cytosol15.510.92No -
C’ GFP library in SD+H2O2

cytosol16.30.97No -
C’ GFP library in Starvation Media

cytosol15.420.92No -
C’ GFP library on the background of Pup2-DaMP

below threshold -
C’ GFP library on the background of CCT mutant

below threshold17.94591.07253No
